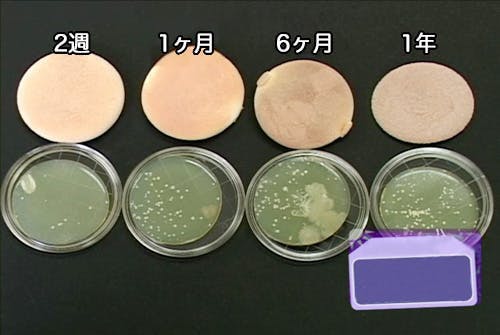

マイクロセルを搭載した韓国発のパフ・ゼリーファームはシリコンパフとスポンジパフのメリットを両方取り入れた新感覚のパフです。

汎用性の高い丸型の「オレンジ」と目元や小鼻など細かいところに適した「ピーチ」の2種類です。


マイクロセルはパフの表面にある超微細な凹凸のことです。マイクロセルパフ一つに8,000個以上あるマイクロセルの働きによってお肌にファンデーションを薄く広げ、均等に密着させることができます。
マイクロセルを搭載したパフは世界雄一ゼリーファームだけです。
(国際特許出願番号PCT KR2018-013427)
衛生的
- スポンジパフとは違いパフに化粧品が吸収されないから微生物繁殖の原因になる残存物の心配がありません。ウェットティッシュで軽く拭いたり、水で洗うことでいつもきれいに使えます。
経済的
- 化粧品がパフ内部に滲みこまないから無駄が省けて、スポンジパフを使うときと比べて1/3まで節約できます。
使い道いろいろ
ファンデーションだけではなく、BBクリーム、サンブロックなど全ての液状化粧品を使うときに便利です。肌に均等に塗ることが最も大事なサンブロックを塗るときにお勧めです。
お肌に優しい
人に無害なシリコン素材にポリウレタンフィルムと使っていますので安全で長く使えます。


日常で何気なく使っているパフ。この小さなパフにも様々な注意点があり、その中には後戻りできないトラブルの原因となる場合も少なからずあります。
スポンジパフは細菌の温床
人間の顔には数万から数千万ものの微生物が生殖しています。中には、肌油の過量分泌を防いだり病原菌を浸透から肌を守るなど生活に欠かせない役割をする微生物が多いですが、その数が多くなったり死骸が毛穴を防いだりしてニキビなどお肌トラブルの原因となることもあります。
誤ったパフの管理は、顔からこのような微生物をパフに移し、さらに増殖させて顔に戻す結果となります。
特にスポンジパフの場合は程よい湿度とファンデーションの残り、肌の角質が混じりあった微生物繁殖に最適な環境を与える恐れがあります。
<パフの使用期間によって増殖された細菌比較>
シリコンパフは使いにくい

使ってすぐ洗い流せるメリットでシリコンパフを使ってみた方は多くいらっしゃいますが、化粧の仕上がりにはいまいちという声もよく聞きます。
一般的にみられるシリコンパフは表面が滑らかで顔と密着しファンデーションを押し出すためノリが悪く、一つのところに固まってムラが付きやすいです。
使用方もシリコンパフを使いにくく思う一つの原因で、スポンジパフに慣れている方はシリコンパフに慣れるまで少しの時間とコツが必要です。

同じ量のリキッドファンデーションを使用したとき、スポンジパフのように無駄に吸収されないから化粧の効率が高くなります。

もちろん、無駄がない分カバー力のアップします。

使った後や汚れたときは洗ったりする必要もなくウェットティッシュで軽く拭くだけでお手入れ簡単!
使い捨てやすぐ使えなるスポンジパフと違って長く使えて環境にやさしい、化粧品の残存物からの細菌の繁殖しないから人にも優しいパフです。

![]()
ファンデを吸収されないから色々なメリットを持つシリコンパフですが、
逆に、つるつるとした表面だからこそのデメリットも多くあります。
ある大手通販サイトに掲載されているシリコンパフのレビューをいくつか紹介します。

肌にフィットしない、むらになる、綺麗にのらない、馴染まない、伸びが悪い、細かいところには使いにくいなどネガティブなレビューも多く目にします。
シリコンの表面がつるつるのウレタンなので防水性が高くファウンデーションを弾いて、お顔にのせたファウンデーションを塗るではなく拭いてしまい、一か所に固まるのがムラ付いたり、馴染まなかったりする原因です。
![]()
ゼリーファームは、
表面に8,000個以上のマイクロセルを施したことで、セルの間にファンデーションを取り込み普通のシリコンパフと比べ伸びが良くお肌に馴染みやすいです。
また、ファンデーションがお顔全体に均等にのり、ムラ付きを防ぎます。


ゼリーファームはスポンジパフと違い、塗り方にも少し異なるところがあります。
まずは、スポンジパフを使用するときと比べ1/3の量を使用する感覚でお顔全体に塗り、やさしくポンポンと叩いて馴染ませる(パッティング)必要ですが、
塗るとパッティングを6:4の割合で行う感覚で仕上げてください。
化粧を直すときは軽いパッティングで直します。

① 化粧品の量はスポンジパフの時より1/3にしてください。
② お肌のキメに沿ってなでるように塗り広げます。
③ 軽いパッティングでお肌に馴染ませます。
④ お化粧直しの時はパッティングで直します。
使い方には少し慣れが必要です。「仕上げパッティング」を念入りに行ってください。

Q:どのくらい使えるんですか?
A:鋭いもので刺して中のシリコンが漏れてしまう物理的な損傷がない限り半永久的にご利用頂けます。
Q:お手入れはどのようにすればいいですか?
A:使用後すぐウェットティッシュで拭くか、水で軽く洗ってから水分を切って保管してください。
変色の原因となりますので、直射日光を避けて保管してください。
Q:クッションファンデーションにも使えますか?
A:ゼリーファームはシリコンパフとは違い、クッションファンデーションにも対応しております。
スポンジクッションを使用するときより1/2の量を軽い力で塗り、パッティングを細目に行ってください。


パッケージのパフの周りを取り出すとパフケースとして使えます。
※パッケージのデザイン、言語等の仕様は品質及びサービス向上のため
変更される場合が御座います。
パッケージ変更を含むすべての変更事項は
本ページにてご報告いたします。


ご注意
1.パプを包むウレタン幕は絶対に剥がさないでください。
(シリコンが漏れてしまいご利用頂けない恐れが御座います。)
2.本体を切ったり、鋭いもので刺したりしないでください。
3.パフ以外の目的で使用しないでください。
4.幼児の手に届かない場所に保管してください。
5.化粧品の色がついてしまう場合が御座いますが、仕様上問題は御座いません。
最新の活動報告
もっと見るリターンの発送が終了されました。
2019/06/20 16:14こちらの活動報告は支援者限定の公開です。





コメント
もっと見る